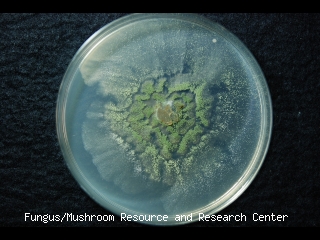
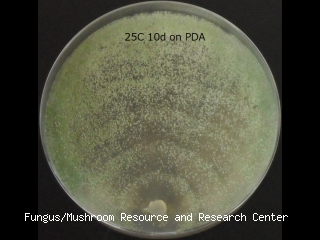

Taxonomic information
- TUFC No.
- 61530
- Division
- Ascomycota
- Class
- Sordariomycetes
- Subclass
- Hypocreomycetidae
- Order
- Hypocreales
- Fungus Name
- Trichoderma mienum C.S. Kim, Nakagiri & N. Maek.
- Reception Name
- Hypocrea sp.
Information of deposit, history of strain et al.
- Date of deposit
- 2005/04/01
- Registered by
- N. Maekawa
- Affiliation
- TMI
- History
- <- TMIC 61530 <- M. Komatsu (TMI)
- Former names
- Hypocrea sp. until 2012
- Other collection no.
- TMIC 61530
Information of collector, source et al.
- Date
- 1987/02/03
- Identified by
- C. S. Kim
- Affiliation
- UGSAS
- Isolated by
- M. Komatsu
- Affiliation
- TMI
- Source of isolation
- Regenerated mycelium
- Isolation method
- Mycelium isolation
Collected location
- Habitat
- On bedlog of oyster mushroom
- Locality
- Kuwana-shi, Mie Pref., Japan
Information of voucher specimen
Photo(s)
Sequence information
- Sequenced region 3
- ELF
- Sequence Data 3
- >d61530_ef1_20120927_KO TCAAATTCCCCCTCTTCTCATGCACTTGTCGAACGAATCTGCGCGTCGATAATTCTGTCCCTTCTGCATCATCACCCCGCTCTCGTTGACTACCCCTCCTTTGCAGCGAGGCAAATTTTTTTTGGCTACCAATATTTTTTTGGTGGGGGTAACTCATGTAGCGACCCCACCGCAGCCTCGGGCTGCTTCATGCCTTTCTCTACCACACACGATTTGCCCATTCAACTCATTCACATCAAGCTCCAACGCCTTCACTTGTTACTTTCAGCGATGCTAAGCATGTTCCTCTCTACAGGAAGCCGCCGAACTCGGCAAGGGTTCCTTCAAGTACGCGTGGGTTCTTGACAAGCTCAAGGCCGAGCGTGAGCGTGGTATCACCATCGACATTGCCCTCTGGAAGTTCGAGACTCCCAAGTACTATGTCACCGTCATTGGTATGTTTCCTTGATGACTTTCATTCAATATGCACGAGCCAGCGCTAATACAAATCTGGCAGACGCTCCCGGCCACCGTGATTTCATCAAGAACATGATCACTGGTACTTCCCAGGCTGACTGCGCT
Unauthorized copying and replication of the contents of this site, text and images are strictly prohibited.
Reference(s)
- Reference 1
- Kim, C.S., Shirouzu, T., Nakagiri, A., Sotome, K., Nagasawa, E. and Maekawa, N.. 2012. Trichoderma mienum sp. nov., isolated from mushroom farms in Japan. Antonie van Leeuwenhoek. 102: 629-641
Additional information
- Biosafety level
- L1
- Physical containment
- P1
- Medium
- MA
- Incubation temp.
- 25 ℃
- Comment
- JQ621971 (ITS), JQ621976 (tef1), JQ621966 (rpb2)
- Date of released
- 2013/05/01
- Date of last modified
- 2017/02/12